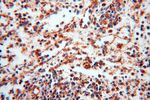
NDUFB7 Antibody in Immunohistochemistry (Paraffin) (IHC (P))

Search
Proteintech
NDUFB7 Polyclonal Antibody
{{$productOrderCtrl.translations['antibody.pdp.commerceCard.promotion.promotions']}}
{{$productOrderCtrl.translations['antibody.pdp.commerceCard.promotion.viewpromo']}}
{{$productOrderCtrl.translations['antibody.pdp.commerceCard.promotion.promocode']}}: {{promo.promoCode}} {{promo.promoTitle}} {{promo.promoDescription}}. {{$productOrderCtrl.translations['antibody.pdp.commerceCard.promotion.learnmore']}}
产品信息
14912-1-AP
种属反应
已发表种属
宿主/亚型
分类
类型
抗原
偶联物
形式
浓度
规格
纯化类型
保存液
内含物
保存条件
运输条件
产品详细信息
Immunogen sequence: MGAHLVRRY LGDASVEPDP LQMPTFPPDY GFPERKEREM VATQQEMMDA QLRLQLRDYC AHHLIRLLKC KRDSFPNFLA CKQERHDWDY CEHRDYVMRM KEFERERRLL QRKKRREKKA AELAKGQGPG EVDPKVAL (1-137 aa encoded by BC002595)
靶标信息
The protein encoded by this gene is a subunit of the multisubunit NADH:ubiquinone oxidoreductase. Mammalian complex I is composed of 45 different subunits. It is located at the mitochondrial inner membrane. This protein has NADH dehydrogenase activity and oxidoreductase activity. It transfers electrons from NADH to the respiratory chain. The immediate electron acceptor for the enzyme is believed to be ubiquinone.
仅用于科研。不用于诊断过程。未经明确授权不得转售。
生物信息学
蛋白别名: cell adhesion protein (SQM1); Cell adhesion protein SQM1; CI-B18; CI-B18; complex I-B18; complex I B18 subunit; Complex I-B18; NADH dehydrogenase (ubiquinone) 1 beta subcomplex, 7, 18kDa; NADH dehydrogenase [ubiquinone] 1 beta subcomplex subunit 7; NADH-ubiquinone oxidoreductase B18 subunit; NDUFB7; stuctural complex I protein
基因别名: 1110002H15Rik; B18; CI-B18; MC1DN39; NDUFB7
UniProt ID: (Human) P17568, (Mouse) Q9CR61
Entrez Gene ID: (Human) 4713, (Mouse) 66916, (Rat) 361385